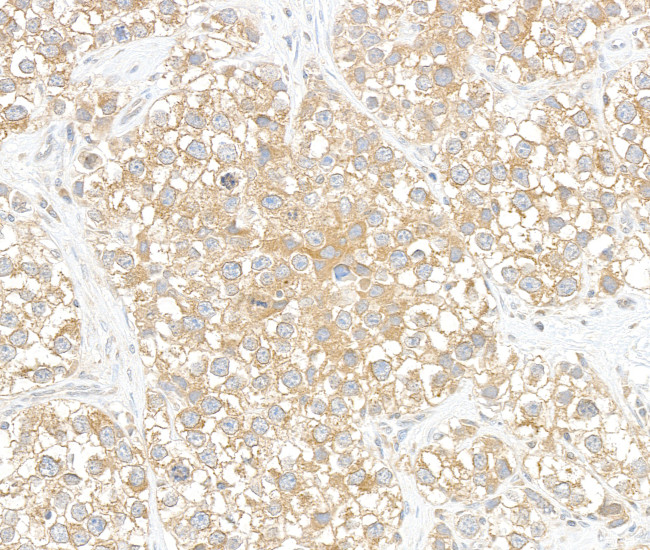
BIG1/ARFGEF1 Antibody in Immunohistochemistry (Paraffin) (IHC (P))

Search
Bethyl Laboratories
BIG1/ARFGEF1 Polyclonal Antibody
{{$productOrderCtrl.translations['antibody.pdp.commerceCard.promotion.promotions']}}
{{$productOrderCtrl.translations['antibody.pdp.commerceCard.promotion.viewpromo']}}
{{$productOrderCtrl.translations['antibody.pdp.commerceCard.promotion.promocode']}}: {{promo.promoCode}} {{promo.promoTitle}} {{promo.promoDescription}}. {{$productOrderCtrl.translations['antibody.pdp.commerceCard.promotion.learnmore']}}
图: 1 / 4
BIG1/ARFGEF1 Antibody (A300-998A) in IHC (P)




产品信息
A300-998A
种属反应
宿主/亚型
分类
类型
抗原
偶联物
形式
浓度
规格
纯化类型
保存液
内含物
保存条件
运输条件
产品详细信息
The recommended shelf life for this product is 1 year from date of receipt.
Application Note: For IHC, epitope retrieval with Tris-EDTA pH 9.0 is recommended for FFPE tissue sections.
Based on 100% sequence identity, this antibody is predicted to react with Rat and Bovine
靶标信息
The function of this protein remains unknown.
仅用于科研。不用于诊断过程。未经明确授权不得转售。
篇参考文献 (0)
生物信息学
蛋白别名: ADP ribosylation factor guanine nucleotide exchange factor 1; ADP-ribosylation factor guanine nucleotide-exchange factor 1; ADP-ribosylation factor guanine nucleotide-exchange factor 1 (brefeldin A-inhibited); BIG1; Brefeldin A-inhibited GEP 1; Brefeldin A-inhibited guanine nucleotide-exchange protein 1; DKFZP434L057; p200 ARF guanine nucleotide exchange factor; p200 ARF-GEP1; unnamed protein product
基因别名: ARFGEF1; ARFGEP1; BIG1; D130059B05Rik; D730028O18Rik; DEDISB; P200
UniProt ID: (Human) Q9Y6D6, (Mouse) G3X9K3
Entrez Gene ID: (Human) 10565, (Mouse) 211673